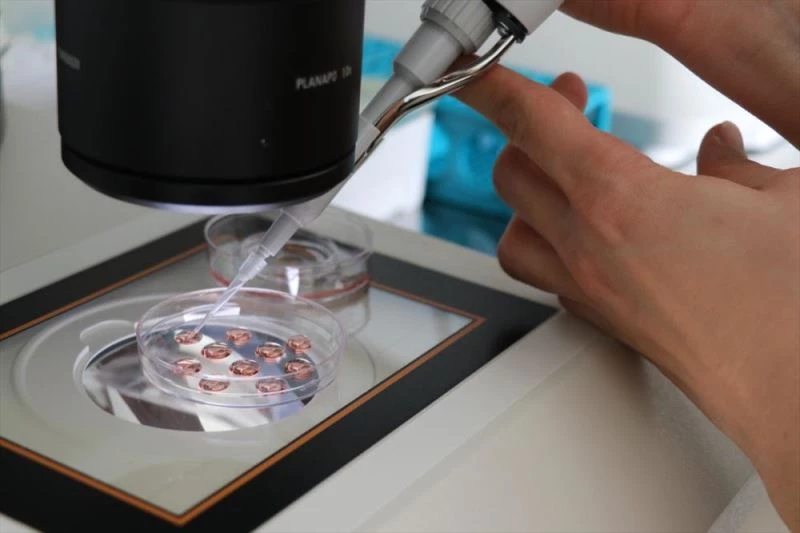
Yüksek genetikli boğalar yetiştirip ithalatın azaltılması hedefleniyor

BURDUR - BİLAL ALTIOK - Burdur Mehmet Akif Ersoy Üniversitesi (MAKÜ) tarafından 2017'de hayata geçirilen proje kapsamında embriyodan üretilen yüksek genetikli düve ve boğalar yetiştirilerek ülkedeki sperma ve embriyo ithalatının azaltılması amaçlanıyor.
Üniversitenin İstiklal yerleşkesindeki büyükbaş hayvan çiftliğinde kurulan MAKÜ Genetik ve Embriyo Teknolojileri Uygulama ve Araştırma Merkezinde, ineklere embriyo transferleri yapıldı.
Yurt dışından getirilen yüksek verimli "Holstein" olarak da bilinen "siyah alaca" cinsi embriyolar taşıyıcı ineklere nakledildi, 2,5 yılda yüksek verimli 45 düve üretildi. Bu 45 düveden elde edilen embriyolarla bu düveler ile başka taşıyıcı inekler de gebe kaldı.
Üniversiteden sahaya taşınarak ülke genelinde yaygınlaştırılması amaçlanan çalışmayla çiftlikte normalde ömrü boyunca 4-5 buzağı veren bir inekten verimli ve kalitesi yüksek 50-60 civarında buzağı elde edilmesi ile yetiştirilen yüksek genetikli boğalardan sperma üretimi hedefleniyor.
Veteriner Fakültesi Doğum ve Jinekoloji Anabilim Dalı Öğretim Üyesi Embriyo transfer yürütücüsü Prof. Dr. Yunus Çetin, AA muhabirine, MAKÜ'nün YÖK ve Cumhurbaşkanlığı Strateji Daire Başkanlığınca ortaklaşa desteklenen projeyle hayvancılıkta ihtisaslaşan üniversite olduğunu söyledi.
Bu misyonla üniversitede çalışmalar yürüttüklerini bildiren Çetin, dünyada yılda yaklaşık 1 buçuk milyon civarında embriyo transferi yapıldığını anlattı.
Çetin, bu teknolojiyle normalde verimi yüksek bir ineğin ömründe doğurabileceği hayvanın 10 katını bir yılda alınabildiğine dikkati çekerek embriyo transferinin hayvancılıkta ciddi bir avantaj ve zamandan tasarruf sağladığını vurguladı.
- "İthalatın çok büyük bir kısmının önüne geçmek mümkün"
Et ve süt verimi açısından yüksek genetikli sperma konusunda Türkiye'nin ithalata bağımlı olduğunu bildiren Çetin, "Yılda yaklaşık 7-7 buçuk milyon doz yüksek genetikli sperma ithal ediyoruz. Böyle bir projeyi uygulayıp kendi boğalarımızı yetiştirerek bu ithalatın çok büyük bir kısmının önüne geçmek mümkün. Bir boğa yıllık 40 bin, 50 bin doz gibi yüksek miktarda sperma üretebiliyor. Bu amaçla biz öncelikle ABD'den ithal ettiğimiz embriyolarla yüksek genetikli yüzde yüz saf bir sürü oluşturduk." diye konuştu.
- "Yüksek genetikli hem erkek hem de dişi yavrularımız olacak"
Çetin, yüksek genetikli doğan 45 düveden embriyo ürettiklerine dikkati çekerek, "Önümüzdeki yıl bizim yüksek genetikli hem erkek hem de dişi yavrularımız olacak. Erkekleri sperma boğası üretimi için kullanacağız. Bir aksaklık olmazsa 15-20 arasında erkek yavru almayı hedefliyoruz. Sonraki yıllarda sayı artarak devam edecek." ifadelerini kullandı.
Embriyo transferinin dünyada daha yaygın kullanıldığını, Türkiye'de bu teknolojinin emekleme aşamasında olduğuna değinen Çetin, ülkede bu yönteme ilginin her geçen gün arttığını aktardı.
- "Seyyar embriyo transfer aracı oluşturuldu"
Çetin, bu alanda yetişmiş insan gücünü de artırmaya yönelik çalıştıklarını aktararak şöyle konuştu:
"Bu projenin esas katkısı burada üreteceğimiz boğa adaylarıyla olacak çünkü boğalar sadece Burdur'da kullanılmayacak. Bunların spermaları tüm Türkiye'de kullanılacak ve ülkeye katma değer oluşturacak. Biz oluşturduğumuz bir mobil aracımızla merkezdeki gibi bir laboratuvarı seyyar hale getirdik. Yani laboratuvar artık seyyar. Böylece bu teknolojiyi kullanmak isteyen çiftliklerimizi embriyo transferine yatırım yapmaktan kurtarıyoruz"
Çetin, ülkedeki embriyo transferindeki yasal mevzuatın bazı sınırlamaları doğurduğunu dile getirerek bu konudaki sorunların düzeltilmesini Tarım ve Orman Bakanlığıyla görüştüklerini, mevzuatın yakında iyileştirilmesi umduklarını kaydetti.